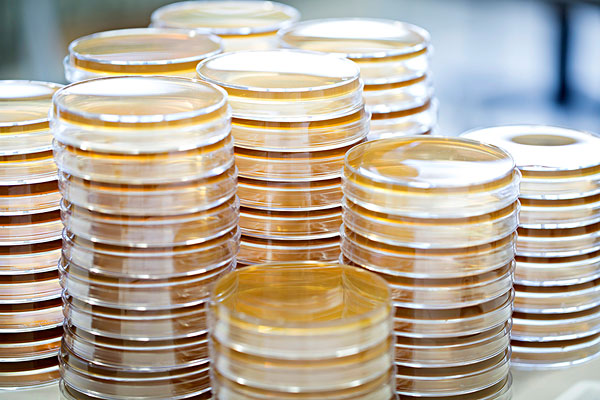

微生物检测
技术简介
微生物包括细菌、病毒、霉菌、酵母菌等。病毒是一类由核酸和蛋白质等少数几种成分组成的“非细胞生物”,但是它的生存必须依赖于活细胞。
近年来,食品、饮用水、农产品、生活用品等方面由微生物引起的污染突发事件频繁发生,微生物污染已成为我们乃至全球的头号问题。
应用分子生物学方法从遗传进化角度阐明微生物种群之间的分类学关系,是目前微生物分类学研究普遍采用的鉴定方法。科标检测拥有微生物菌种分类鉴定的分子生物学实验室,配有PCR仪、高速冷冻离心机、电泳仪、HPLC、凝胶成像系统、紫外控温分析系统等先进仪器设备,以及DNAMAN、BIOEDIT、CLUSTALX、TREEVIEW等序列分析软件。目前科标检测研究院可采用核酸序列分析法分析细菌16S rDNA/16S-23S rDNA区间序列、酵母18S rDNA/26S rDNA(D1/D2)序列及丝状真菌的18S rDNA/ ITS1-5.8S-ITS2序列,提供科学的鉴定结果。
我公司提供以分子检测为基础微生物的菌种鉴定,菌种数及抗性菌检测,微生物的培养、分离、纯化,基因工程菌株构建及发酵产物的鉴定等服务。
应用领域
1. 食品、卫生、农业、微生物发酵等领域的微生物鉴定。
2. 基因工程菌构建。
服务内容
| 服务项目 | 服务内容 |
| 微生物培养 | 微生物培养基及培养条件优化 |
| 微生物分离、纯化 | 多种抗性培养基筛选,进行分离、纯化,抗性菌检测 |
| 菌种鉴定 | 依据基因序列比对,如细菌16srDNA、真菌18srDNA\ITS鉴定,用于鉴定菌种,菌种数测定等。 |
| 基因工程菌株构建 | 根据客户需求,构建相应的基因工程菌 |
| 发酵产物鉴定 | 对微生物发酵产物通过GC-MS、LC-MS进行鉴定 |
技术优势
1. 拥有齐全的设备、先进仪器、创新检验技术的全方位实验室。
2. 可对多种样品如食品、药品、水质、日化等提供微生物检测。
服务流程
客户在线下单-订单/实验材料确认——{1. 增菌——分纯——初步鉴别实验(革兰氏染色、抗生素敏感性试验等);2. DNA提取-PCR扩增(16srDNA、18srDNA、ITS等)——克隆测序——序列比对-鉴定结果分析
您需要提供以下材料
1. 需要检测的微生物样本
2. 具体的实验要求
您将获得的实验结果
1. 实验报告,报告实验流程、方法、结果分析等
2. 微生物分离培养照片、DNA提取电泳图等